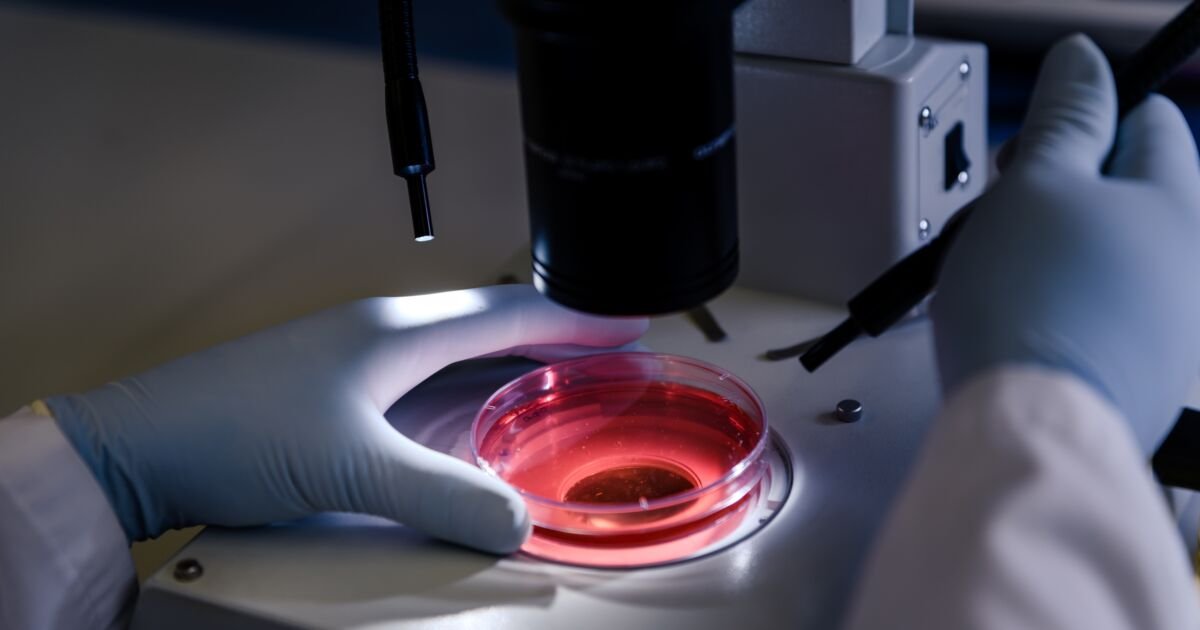
Aumento Alarmante: Casos de Leucemia no Brasil Crescem 150% em Uma Década

Aumento dos Casos de Leucemia no Brasil: Estimativa de 12.220 Diagnósticos em 2023
Brasília – O Instituto Nacional do Câncer (INCA) divulgou recentemente a Estimativa 2026, que aponta que 12.220 brasileiros devem ser diagnosticados com leucemia neste ano. Este número representa um aumento de 21% em relação aos 10.070 casos previstos há dez anos. A população brasileira, segundo dados do Instituto Brasileiro de Geografia e Estatística (IBGE), cresceu 3,5% entre 2016 e 2025, o que pode refletir nas novas incidências.
A hematologista Renata Lyrio, da Oncologia D’Or, atribui esse crescimento à combinação do envelhecimento da população e à melhoria nos métodos de diagnóstico. “Apesar do aumento no número de casos, a gravidade da doença tem diminuído, graças aos avanços nos tratamentos, que promovem uma melhor qualidade de vida para os pacientes”, afirma a especialista.
O mês de fevereiro é marcado pela campanha Fevereiro Laranja, que visa conscientizar a população sobre a leucemia, caracterizada pela proliferação desordenada de células brancas na medula óssea, que substituem as células saudáveis. Essa neoplasia é mais comum entre homens, com maior incidência em crianças até quatro anos e em idosos a partir dos 70 anos.
Impactos Globais da Leucemia
Um estudo recente realizado na China analisou o impacto da leucemia em 204 países entre 1990 e 2021, revelando um aumento de 28% nos casos. Entretanto, também foi observada uma redução de 16% nos anos de vida perdidos devido a mortes prematuras ou incapacidade, usando a métrica DALY (Disability-Adjusted Life Year). Os avanços terapêuticos, como medicamentos mais eficazes e seguros, têm contribuído para essa melhoria.
No entanto, nem todos os países se beneficiam igualmente. Regiões de baixa renda ainda enfrentam altos índices de mortalidade e diagnósticos tardios. No Brasil, a dificuldade de acesso aos serviços de saúde em algumas áreas atrasa o diagnóstico e o tratamento, prejudicando os resultados.
Leucemia no Brasil: Estatísticas e Classificação
No Brasil, a leucemia ocupa a 13ª posição entre os tipos de câncer mais frequentes. Ela é o sexto câncer mais comum entre homens no Nordeste e o sétimo no Norte, enquanto nas mulheres ocupa a nona posição nessas regiões.
A leucemia é classificada em aguda e crônica, dependendo da rapidez de sua progressão. As formas agudas são mais agressivas e apresentam sintomas como fadiga, febre e sangramentos em poucas semanas. Já as leucemias crônicas desenvolvem-se de maneira mais lenta, com sintomas que podem levar meses ou anos para aparecer.
Diagnóstico e Tratamento
O diagnóstico de leucemia, como a Leucemia Mieloide Aguda (LMA) e a Leucemia Linfoblástica Aguda (LLA), requer exames de medula óssea e análise genética. Já as leucemias crônicas podem ser diagnosticadas com a coleta de sangue periférico.
O tratamento varia conforme o tipo de leucemia e a idade do paciente. A quimioterapia é a abordagem mais comum para as formas agudas, enquanto as leucemias crônicas frequentemente utilizam terapias-alvo, que são menos tóxicas e mais eficazes.
Entre os fatores de risco modificáveis, destacam-se o controle do peso, a interrupção do tabagismo e a redução da exposição a substâncias carcinogênicas, como o benzeno. Renata Lyrio recomenda também a prática regular de atividades físicas, uma alimentação balanceada e um sono de qualidade. “Consultas médicas anuais e a realização de hemogramas podem ser fundamentais para a detecção precoce da doença”, conclui a hematologista.
A conscientização e a informação são essenciais para o enfrentamento da leucemia, especialmente durante a campanha Fevereiro Laranja, que busca alertar a população sobre a importância do diagnóstico precoce e do acesso a tratamentos adequados.
Fonte: Link original